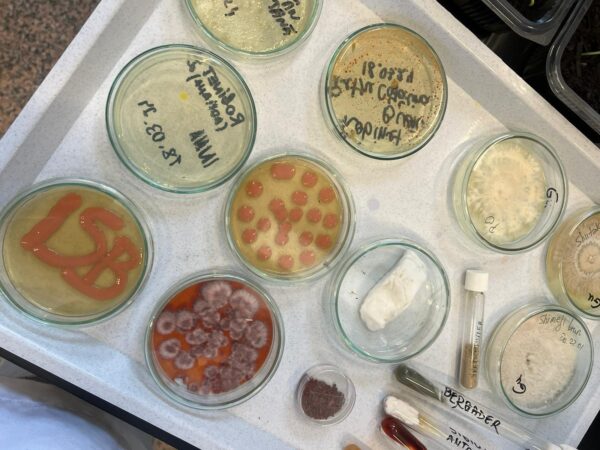

Ultimele articole
Reportaj
REPORTAJ | Vocile oamenilor muncii, „îngropate” de dictatură. Povești mai puțin cunoscute ale Capitalei, din „Epoca de Aur”
Poveștile oamenilor obișnuiți din perioada anilor ‘80, cu emoția, suferințele și idealurile lor sunt duse mai departe de Asociația București. Turul ghidat „Victoria...
deAndreea Tudor01/05/2024REPORTAJ | A doua „moarte” a unui monument: Hala Matache, uitată de peste un deceniu în depozitul celui care a dărâmat-o. 160.000 de euro, factura pentru PMB
„Cronica unei morți anunțate” Legalitatea proiectului a fost contestată de mai mulți actori ai societății civile, printre care și Nicușor Dan, actualul primar...
deAndreea Tudor22/04/2024REPORTAJ | „Am fost la Festivalul Oamenilor Deștepți de la Poli iar acum vreau să fiu studentă la bioinginerie!”
Bună, dragi prieteni! Habar nu aveți ce mândră am fost când șefii mei m-au anunțat că au atât de multă încredere în mine,...
deLisa Nedelcoff21/04/2024REPORTAJ | Oameni, butoane și ecrane: „Managementul haosului” de la Centrul de Control al Traficului și chestiunea „siguranței naţionale”
Nimic din ambuteiajele atât de binecunoscute bucureştenilor nu te-ar duce cu gândul la artă. Totuşi, du-te vino-ul continuu de pe arterele capitalei, deşi...
deIonuț Lepa11/04/2024REPORTAJ | „După vânătoarea de `pokemoni` din Sectorul 6, vreau amenzi maxime pentru cei care nu strâng după cățeii lor”
Bună, dragi prieteni! Ieri am fost pe teren din nou! E primăvară afară, e încă frumos și pot ieși la ce oră vreau...
deLisa Nedelcoff07/04/2024REPORTAJ | Cultura capătă „dinţi”, în Capitală: Grevă de avertisment, urmată de proteste în „Noaptea Muzeelor”
UPDATE 6 aprilie// Tot vineri, 5 aprilie, ministrul Culturii, Raluca Turcan a declarat că „actul normativ este pregătit”, în urma discuțiilor cu ministrul...
deAdina Căpîlnean05/04/2024REPORTAJ | Cum ar putea fi preparat cozonacul viitorului. Ingredientul secret propus de specialiştii de la Politehnică
Când te gândeşti la cozonac, parcă deja mireasma aceea dulce de dolofan abia scos din cuptor îţi gâdilă nările, iar imaginea este a...
deIonuț Lepa30/03/2024REPORTAJ | Steaua Speranţei, adăpostul „fugarului” Cappuccino. Colegii săi, Hermes şi Dănuț, „maeştrii evadărilor”
Lihniţi de foame, biciuiţi fără milă, folosiţi doar pentru profit şi abandonaţi la marginea drumului odată ce nu mai pot căra… aceasta este...
deAndreea Tudor30/03/2024REPORTAJ | „SpectActorii” de pe scena Teatrului de Comedie
Prolog Contrar credinţei populare, teatrul nu este despre a purta o mască, ci despre a renunţa la ea. Cu toţii purtăm măşti în...
deAndreea Tudor23/03/2024REPORTAJ | Drona alimentată cu hidrogen care ar putea face livrări în Bucureşti, peste câţiva ani. Prototipul a fost expus la EnergyFest
Ce-ar fi dacă? Ce-ar fi dacă în loc de sunetul motoarelor ori al scuterelor turate conduse care pe trotuar, care pe lângă trotuar,...
deIonuț Lepa16/03/2024